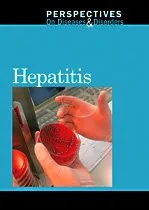

עובדות ומידע מעניין על הספר

עובדות ומידע מעניין על הספר
חברי הקהילה שסימנו שהם קוראים את הספר כרגע
מה חברי הקהילה חושבים על הספר
הצעות מחברי הקהילה וחנויות מקוונות
אין מוכרים זמינים כרגע
מי כתב את הספר

2 ספרים

2 ספרים
לא מצאתם איפה לקנות? בקשו עזרה מהקהילה
רשימות שבהן חברי הקהילה שמרו את הספר
חברי הקהילה שסימנו שהם קוראים את הספר כרגע
מה חברי הקהילה חושבים על הספר
הצעות מחברי הקהילה וחנויות מקוונות
אין מוכרים זמינים כרגע
מי כתב את הספר

2 ספרים

2 ספרים
לא מצאתם איפה לקנות? בקשו עזרה מהקהילה
רשימות שבהן חברי הקהילה שמרו את הספר